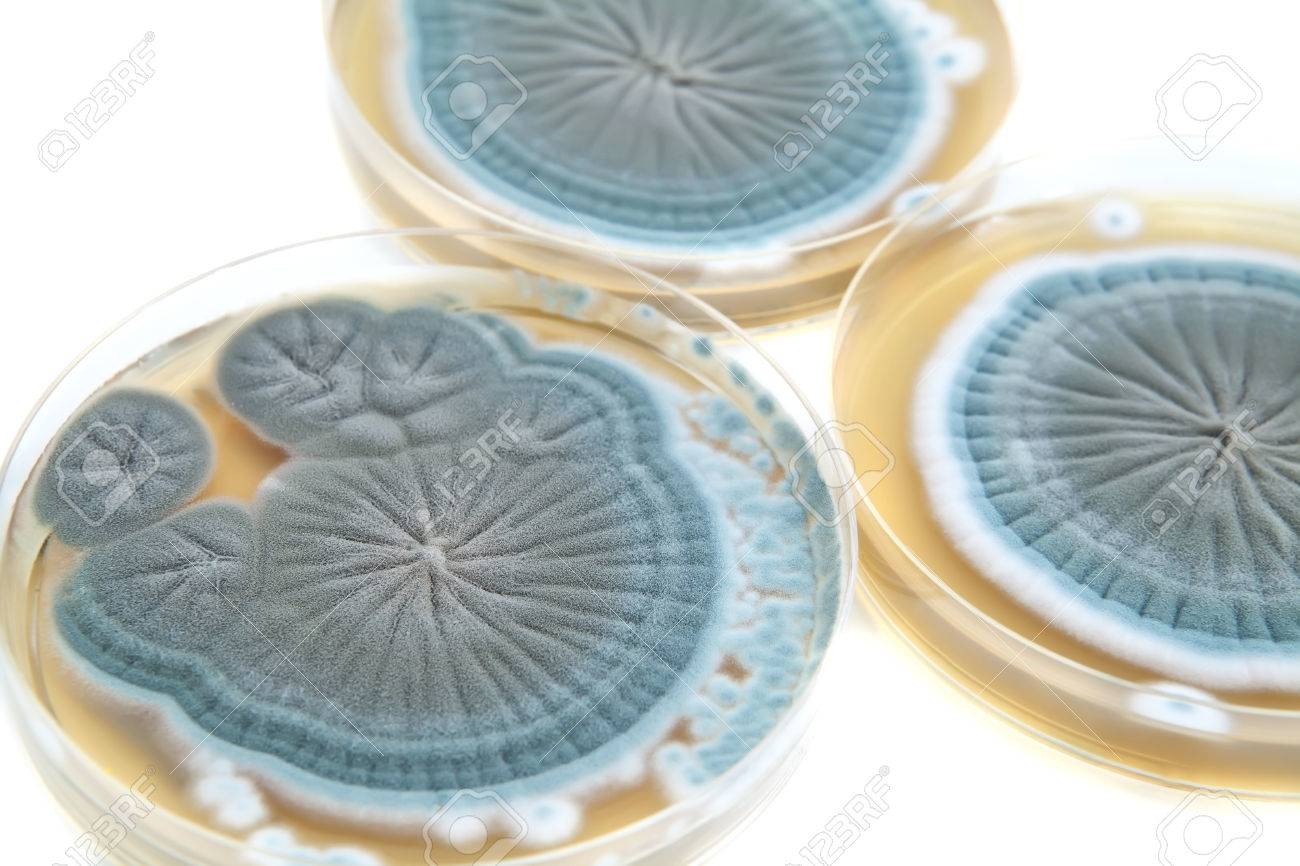
etiam-dictum-ipsum-a-felis

Download
Close
Автор:
id:
Ключевые слова:
agar, agar plate, antibiotics, biology, biotechnology, blue, bright, close up, closeup, drugs, education, experiment, few, fungi, genetics, getecisally, grow, investigation, isolated, laboratory, macro, measure, medical, medicine, microbiology, microorganisms, modification, modify, object, organisms, penicillin, penicillium, petri dish, plate, research, science, shape, study, texture,





